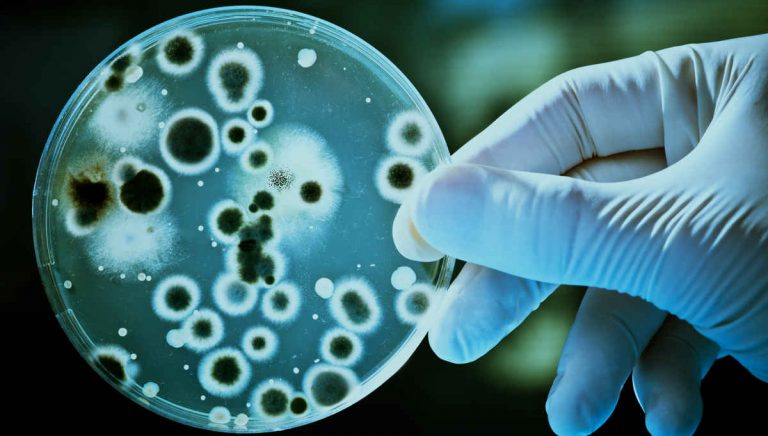

UNEPI organiza una capacitación La biotecnología, ciencia aplicada con potencial para el desarrollo productivo
Entre el 1 y 12 de setiembre próximo, en modalidad virtual, habrá una capacitación sobre “Biotecnología, es hora de comprender más y temer menos”, dirigida a emprendedores, profesionales y estudiantes, docentes, comunicadores y toda persona interesada en aprender qué es la biotecnología y sus aplicaciones.
La capacitación es organizada por la Unidad de Emprendurismo, Prospectiva e Innovación (UNEPI de la Facultad de Tecnología y Ciencias Aplicadas de la Universidad Nacional de Catamarca (UNCA) y el Consejo Argentino para la Información y el Desarrollo de la Biotecnología.
El Consejo Argentino para la Información y el Desarrollo de la Biotecnología (ArgenBio) es una institución sin fines de lucro, creada en 2003 con la misión de divulgar información sobre biotecnología, contribuyendo a su comprensión a través de la educación y estimulando su desarrollo.
Contenidos destacados: biotecnología tradicional y moderna: historia, definiciones y aplicaciones; mejoramiento animal y vegetal, cultivos transgénicos y nuevas técnicas; biotecnología y medio ambiente; comunicación científica y combate a la desinformación.
El 1 de setiembre se habilita la plataforma online y los participantes podrán realizar las actividades de manera asincrónica. El cierre sincrónico en vivo se realizará el 10 de setiembre por Meet o You Tube de 18:30 a 20. Entre el 10 y 12 de setiembre está programado el final de las actividades y entrega de evaluación.
La Unidad de Emprendedurismo, Prospectiva e Innovación, considera que “la biotecnología es una ciencia aplicada con enorme potencial para el desarrollo productivo y sustentable de Catamarca, gracias a la riqueza de nuestros recursos naturales y a las oportunidades que brinda la innovación”.
“Desde la Facultad de Tecnología y Ciencias Aplicadas, a través de la UNEPI, estamos comprometidos con fomentar el conocimiento y la formación en áreas estratégicas como esta, que pueden generar valor agregado, empleo calificado y soluciones innovadoras para nuestra provincia”, recalcan.
Y advierten que “si queremos aprovechar el potencial de la biotecnología en Catamarca, primero tenemos que conocer de qué se trata”. ¡Te esperamos para aprender, debatir y proyectar juntos el futuro!, reza la invitación a participar de la capacitación que tendrá carácter gratuito. Por inscripciones, https://forms.gle/nRwG3BS6JbsVmqYf7
El valor y la importancia de la biotecnología
Si hay una rama de la ciencia que ha revolucionado la investigación científica del siglo XXI esa es la biotecnología. A pesar de los múltiples beneficios de la biotecnología, un porcentaje muy significativo de la población no conoce en qué consiste esta disciplina científica ni qué campos aborda
Se entiende por biotecnología toda aplicación tecnológica que utilice sistemas biológicos y organismos vivos o sus derivados para la creación o modificación de productos o procesos para usos específicos. De hecho, la biotecnología (junto a la bioquímica y la biología molecular) es en la actualidad la primera disciplina en porcentaje de contribuciones científicas e impacto en el contexto internacional.
Las biociencias moleculares y sus aplicaciones biotecnológicas están consideradas, después de las tecnologías de la información, la siguiente gran ola de expansión de la economía basada en el conocimiento.
Son cada vez más las empresas que invierten y realizan actividades relacionadas con la biotecnología. Estos datos se justifican por el número de aplicaciones que tiene la biotecnología en áreas tan aparentemente diferentes como alimentación, medicina, medio ambiente, cosmética, agricultura o la lucha contra el bioterrorismo.
Otro de los valores añadidos de la biotecnología es que se trata de un área multi e interdisciplinar, que se apoya en otras disciplinas como la biología, química, la fisiología, la ingeniería o la informática para obtener sus resultados.
La biotecnología moderna surge en la década de los ’80, y utiliza técnicas denominadas en su conjunto “ingeniería genética”, para modificar y transferir genes de un organismo a otro. De esta manera es posible producir insulina humana en bacterias y, consecuentemente, mejorar el tratamiento de la diabetes.
Por ingeniería genética también se fabrica la quimosina, enzima clave para la fabricación del queso y que evita el empleo del cuajo en este proceso. La ingeniería genética también es hoy una herramienta fundamental para el mejoramiento de los cultivos vegetales.